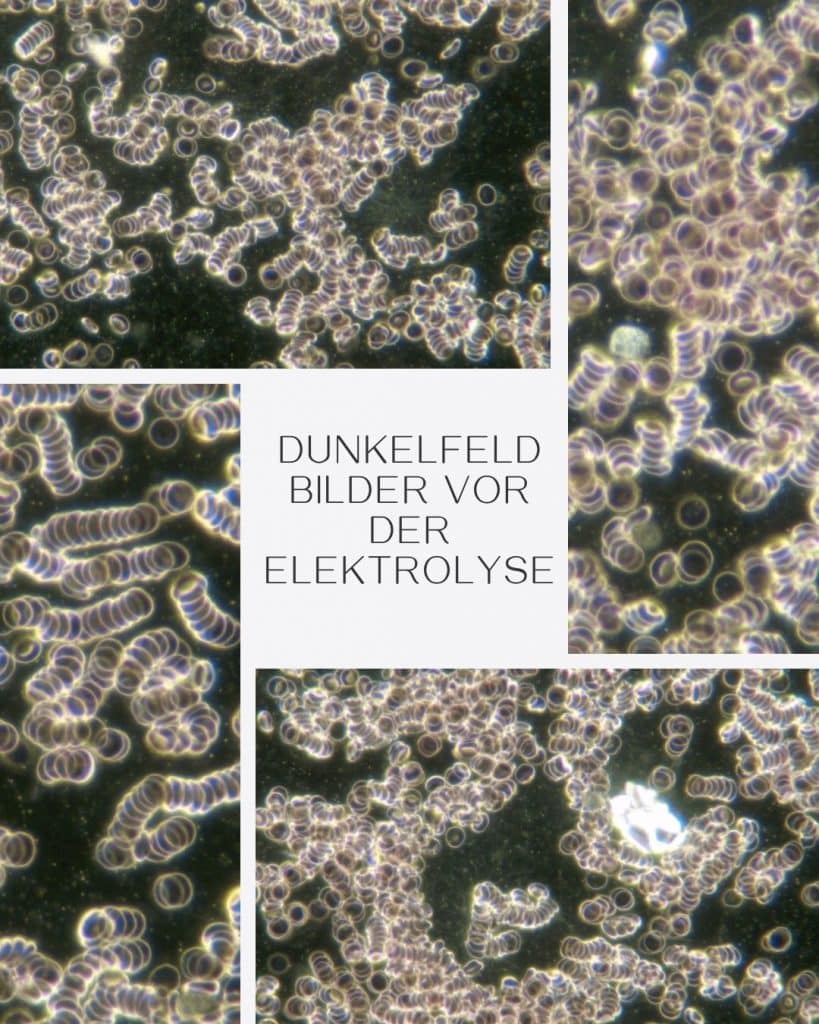
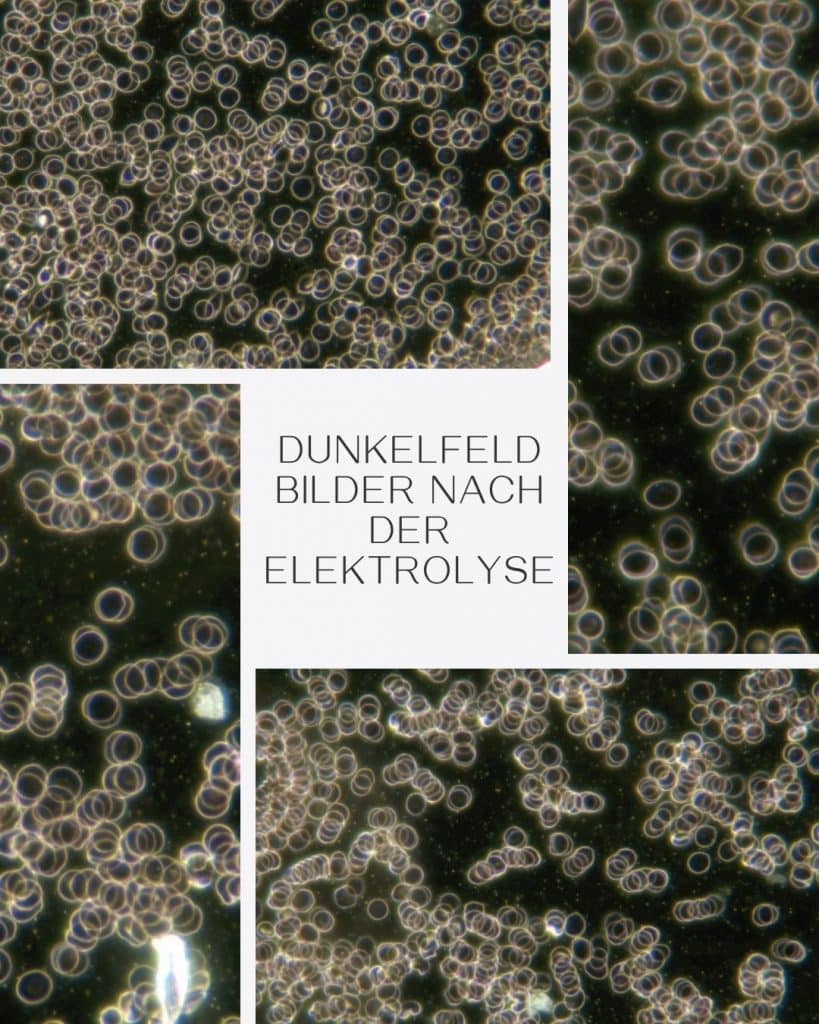

Entgiften mit Elektrolyse
Was versteht man unter einer Entgiftung mit Elektrolyse
Ein Elektrolyse-Bad, auch als Detox-Bad bekannt, dient der Entgiftung des Körpers und der Förderung von Wohlbefinden. Durch die Anwendung von Elektrizität im Wasserbad werden positive und negative Ionen freigesetzt, die Toxine und Schlacken aus dem Körper transportieren und somit die Entgiftung unterstützen
Sie brauchen nur ein wenig Wasser. Die Temperatur kann von jedem Menschen individuell bestimmt werden, die sich dieser Behandlung unterzieht. Es wird ein wenig Himalaya Salz ins Wasser gegeben und los kann es gehen.
Was ist ein Elektrolyse-Fußbad?
Elektrolyse ist ein Prozess, bei dem ein elektrischer Strom eine chemische Reaktion erzwingt. Beim Elektrolyse-Fußbad hält man seine Füße in eine Wanne, gefüllt mit warmem Salzwasser. Eine an ein Steuergerät angeschlossene Spule, die im Salzwasser drin liegt, liefert den Strom
Mit der im Fußbad eingetauchten Elektrode wird eine große Menge von Sauerstoff und negativen Ionen hergestellt, welche das Wasser sättigen.
Über die Haut der Füße, der Hände oder, bei einem Bad sogar über den ganzen Körper, nehmen wir diese im Wasser enthaltene, große Menge von Sauerstoff und negativen Ionen auf, die unseren Zellen, Organen, Eingeweiden und Drüsen wohltun, sie verstärken, durchbluten und versorgen den Körper mit Sauerstoff.
Was bringt ein Elektrolyse Fußbad?
Durch das Detox-Ionen-Fußbad wird Ihr Stoffwechsel angeregt und kann so leichter Stoffwechsel-Abbauprodukte sowie Gifte und Schwermetalle ausscheiden. Diese hemmen die körpereigenen Regulationskräfte und belasten das Immunsystem

Was kann es im Körper bewirken?
Was bewirkt es?
- Bessere Versorgung des Blutes mit Sauerstoff.
- Bessere Versorgung der Gewebe mit Sauerstoff.
- Bessere Versorgung der inneren Organe mit Blut.
- Verbessert die Durchblutung.
- Verbessert den Blutdruck.
- Verbessert die Atemfunktion.
- Verbessert die Drüsenfunktionen.
- Verbessert den Metabolismus.
- Fördert das Ausscheiden von Giftstoffen Anregung des Lymphsytems.
- Fördert das Ausscheiden von Schwermetallen.
- Fördert das Ausscheiden von Amalgammetallen (Zahnfüllungen).
- Fördert die körperliche Erholung nach sportlichen Aktivitäten.
- Fördert den erholsamen Schlaf.
- Fördert die Abgewöhnung von Tabak, Alkohol, Drogen und Arzneimitteln.
- Hilft dem Immunsystem.
Und daher:
- Reagiert das Immunsystem meist besser bei Allergien & Intoleranzen.
- Das Gefühl des Wohlbefindens ist häufig nach der Behandlung zu spüren und kann den ganzen Tag über anhalten.
- Die Vitalität kann verbessert werden.
- Die Erholung von psychophysischem und/oder umweltbedingtem Stress kann stark erleichtert werden.
- Die Erholung von starken körperlichen Anstrengungen kann optimiert werden.
- Die Versorgung des Blutes & des Gewebes mit Sauerstoff kann verbessert werden.
Die Dauer der Behandlung
- Die Behandlung kann nach Belieben 10 Minuten bis 30 Minuten ( je nach Mensch und seinem Anliegen oder Krankheitsbild). Die Intervalle der Wiederholungen ist bei jedem Menschen individuell, man kann es sehr gut Kinesiologisch Testen
Für wen ist es gedacht?
- Für alle, die Wert auf Gesundheit und Wohlbefinden legen
Wie häufig sollte ein Elektrolyse Fußbad – gemacht werden ?
- Die Anwendungen sollten 3 – 4 mal im Monat, über einen Zeitraum von 12 Wochen erfolgen und danach eine Pause von 14 -21 Tagen.
- Wichtig: Trinken Sie vor, während und nach der Anwendung ausreichend Wasser, mindestens zwei Liter


Kontraindikationen
Kontraindikationen:
- Personen mit Organtransplantationen, Herzschrittmacher oder Defibrillator
„Bei der Elektrolyse-Therapie gibt es einige Kontraindikationen, die berücksichtigt werden sollten, um sicherzustellen, dass die Behandlung sicher und effektiv ist. Hier sind einige der häufigsten Kontraindikationen:
Herz-Kreislauf-Erkrankungen:
Personen mit schweren Herzproblemen oder anderen kardiovaskulären Erkrankungen sollten vorsichtig sein, da die Therapie den Blutdruck und die Herzfrequenz beeinflussen kann.
Schwangerschaft:
Schwangere Frauen sollten die Elektrolyse-Therapie vermeiden, da die Auswirkungen auf das ungeborene Kind nicht ausreichend untersucht sind.
Epilepsie:
Menschen mit Epilepsie oder anderen neurologischen Erkrankungen sollten die Therapie meiden, da elektrische Impulse potenziell Anfälle auslösen können.
Metallimplantate:
Personen mit Metallimplantaten, wie z.B. Herzschrittmachern oder anderen elektronischen Geräten, sollten die Elektrolyse-Therapie nicht in Anspruch nehmen, da die elektrischen Ströme die Geräte stören könnten.
Hauterkrankungen:
Bei aktiven Hauterkrankungen oder offenen Wunden sollte die Therapie vermieden werden, um Reizungen oder Infektionen zu verhindern.
Infektionen:
Bei akuten Infektionen oder entzündlichen Erkrankungen sollte die Elektrolyse-Therapie nicht durchgeführt werden, da sie den Heilungsprozess beeinträchtigen könnte.
Allergien:
Personen mit Allergien gegen bestimmte Materialien, die in der Elektrolyse verwendet werden, sollten vorsichtig sein und dies im Voraus mit ihrem Behandler besprechen.
Es ist wichtig, vor Beginn einer Elektrolyse-Therapie eine Anamnese durchzuführen.
Bei weiteren Fragen oder mehr Informationen, stehe ich gerne zur Verfügung!